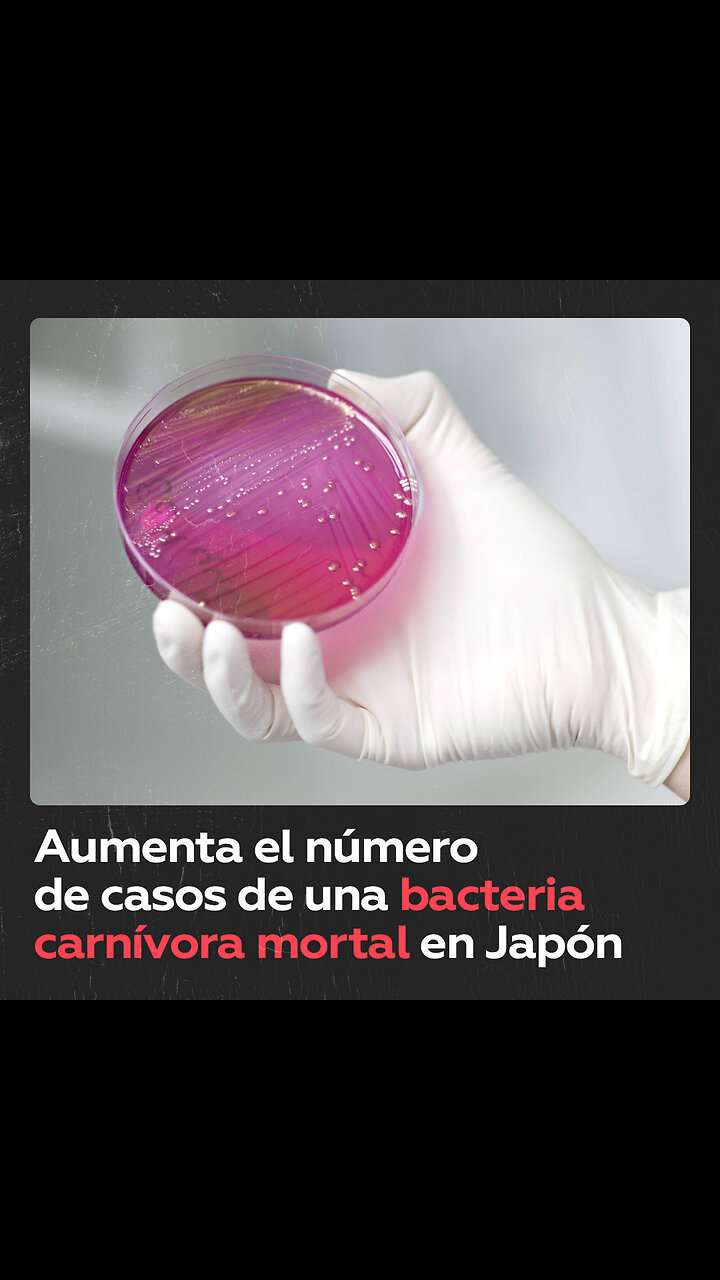
Bacteria capaz de matar a una persona en solo 2 días afecta a Japón

Brasil busca reinsertar a presos en medio de crisis carcelaria
September 26, 2025:El sistema penitenciario de Brasil enfrenta hacinamiento, violencia y alta reincidencia delictiva. Para revertir esta realidad, algunas cárceles impulsan programas de capacitación y empleo para exconv
More Videos from RT en Español

Putin visita un puesto de mando militar y es informado so...
December 01, 2025

Reportan seis muertos en una masacre en una provincia ecu...
November 07, 2025

VERSIÓN COMPLETA: Putin y Trump ofrecen una rueda de pre...
August 15, 2025

RT es el primer medio en llegar a la zona de la batalla f...
November 27, 2025

ZEDE en Honduras: ilusión de progreso y conflictos locales
November 21, 2025

Finaliza el plazo para que la defensa de Jair Bolsonaro p...
October 27, 2025

Israel intercepta la flotilla humanitaria cerca de las ag...
October 02, 2025

Analista: “Alemania no ha sido suficientemente desnazif...
May 09, 2025

Enviado de Trump: Ucrania ha aceptado ceder territorios a...
May 01, 2025

Brasil rompe récord con un colosal monumento a la Virgen
November 17, 2025

Hollman Morris: "Yo temo por la vida hoy del presidente G...
July 29, 2025

Putin visita uno de los puestos de mando del grupo Západ
November 20, 2025

Un trabajador salva a una persona de una tragedia fatal
September 16, 2025

México "podría contrademandar a EE.UU. también" para q...
January 23, 2025

Brasil busca reinsertar a presos en medio de crisis carce...
September 26, 2025

Irán advierte sobre consecuencias catastróficas por da...
June 13, 2025

Una niña hackea la máquina que te robó el dinero cuand...
November 07, 2025

Hombre evita un robo arrojando las llaves y el móvil a s...
December 04, 2025

Putin comenta su reciente reunión con el enviado especia...
December 04, 2025

Trump arremete contra una periodista: "Usted es la report...
December 08, 2025

Zajárova sobre corrupción en Ucrania: un sangriento esq...
November 20, 2025

"Es un tipo inteligente": Trump sobre Putin
August 15, 2025

Se suicida un padre responsable de la muerte de su hija
November 10, 2025

Muere un afroamericano desarmado por disparos policiales
August 06, 2025

Entre apuestas y riesgos, 600 metros de adrenalina
October 05, 2025

Ministro de Defensa de Venezuela: "Somos víctimas, no el...
September 08, 2025

"La mejor noticia" de mamá no era la que sus hijas pensa...
September 15, 2025

Médicos en Gaza operan sin anestesia ni recursos básicos
September 17, 2025

Escuelas de El Salvador refuerzan normas de conducta y pr...
August 22, 2025

Ley Antipandillas en Guatemala: ¿mano dura o seguridad f...
December 02, 2025

Así ayuda un gato a una médica a descifrar un electroca...
November 27, 2025

Así reacciona un perro cuando le hacen cosquillas
November 10, 2025

El motivo por el que Trump confrontó a China
November 11, 2025

Pegaso emerge del Sol: la llamarada más fuerte desde 2024
November 11, 2025

Trump es empujado con la puerta del lavabo de su avión a...
December 09, 2025

Desserto: piel de nopal mexicana que conquista el mundo
September 13, 2025

🐈⬛🚪Por qué no hay que cerrar la puerta a los ...
November 30, 2025

FF.AA. de Venezuela envían contundente mensaje a quienes...
October 24, 2025

¿Cuáles son los frutos secos más saludables?: la respu...
December 07, 2025

🇷🇺 Putin recibe en directo noticias desde la línea...
December 11, 2025

Cristina Martín Jiménez: la Agenda 2030 es un caballo d...
November 24, 2025

Robo insólito de dulces y calabazas durante Halloween
November 05, 2025

Discurso completo de bienvenida del canciller turco
July 23, 2025

Venezolanos marchan en rechazo a las agresiones y la pres...
November 25, 2025

Trump es el ‘Hombre del Año’ según la revista Time
December 12, 2024

Accidente de telesilla deja varios muertos en Rusia
September 17, 2025

Muestra herramientas que podrían haberse usado en la ant...
December 01, 2025

Historia de un "enamoramiento recíproco" entre el públi...
April 04, 2025

"Ya nadie habla de cocaína": Diosdado Cabello desvela la...
November 06, 2025

El proyecto de modernización que divide a la sociedad ho...
November 22, 2025

Saboteadores extranjeros son eliminados en intento de inc...
October 28, 2024

¿Qué une a las culturas rusa y latinoamericana?
October 30, 2025

Kremlin: "La situación para Ucrania es muy difícil"
November 28, 2025

Se intensifican los violentos disturbios en Serbia
August 13, 2025

Pregunta metida con calzador al final de rueda de prensa
November 25, 2025

Tailandia y Camboya reanudan ataques aéreos y combates e...
December 08, 2025

🇧🇷🇺🇦 Familiar de brasileño fallecido denunci...
August 08, 2025

Diosdado Cabello: "Quien ose poner un pie sobre Venezuela...
November 25, 2025

Hombre vestido de mujer se ofende con una joven disfrazad...
November 05, 2025

La Casa Blanca comenta la posibilidad de lanzar un ataque...
August 28, 2025

Tragedia en Brasil: dos jóvenes mueren atropelladas al c...
April 14, 2025

Crisis humanitaria en Gaza: mueren 147 personas por hambre
July 29, 2025

Rusia prueba su triada nuclear durante ejercicios estrat...
October 22, 2025

Zelenski: Lo más importante para Ucrania es "la particip...
December 03, 2025

Una mujer confunde a unos motociclistas con asaltantes
October 29, 2024

Permiten al personal militar de EE.UU. el ingreso en Per...
December 06, 2025

La UE anuncia nuevas sanciones contra Rusia mientras sigu...
October 03, 2024

Rusia y Ucrania realizan un nuevo intercambio de prisione...
June 12, 2025

Funcionario italiano se tropieza y daña con cabeza vidri...
November 17, 2025

Todoterreno Chery provoca daños en monte Tianmen durante...
November 13, 2025

Trump: Israel e Irán violaron ambos el cese al fuego
June 24, 2025

Vehículo volador chino hace historia con su primer traye...
October 16, 2025

Aterriza en Pionyang el primer vuelo directo desde Moscú
July 28, 2025

Trump: "Putin no busca más guerra"
November 21, 2025

La contundente respuesta de Sheinbaum sobre qué haría M...
November 06, 2025

Daniel Ortega rechaza el despliegue de EE.UU. en el Caribe
December 09, 2025

Abogado revela las razones tras las sanciones de EE.UU. c...
October 25, 2025

El desafío de Guatemala para lograr que los migrantes qu...
December 03, 2025

Pasajero graba tornillos sueltos en el ala de un Boeing e...
October 23, 2025

Fuertes lluvias inundan y paralizan un aeropuerto de Moscú
June 08, 2025

Comandante ruso comenta el progreso de la liberación de ...
November 12, 2025

Momento del terremoto en Bangladés captado en directo
November 21, 2025

El bloqueo de EE.UU. a Cuba "es genocidio que afecta a la...
November 06, 2025

Zelenski: “El flujo de armas de EE.UU. a Ucrania se ha ...
July 11, 2025

Carrera nuclear: los expedientes secretos - Documental RT...
October 27, 2025

La historia de Angola
September 11, 2025

Analista: Régimen de Kiev malgasta los fondos de la UE s...
November 20, 2025

Trump: Hablaré con Putin "muy pronto"
September 08, 2025

El manglar ecuatoriano, un tesoro natural en peligro
November 01, 2025

Trump le dijo a Charlie Kirk que podía ser presidente
September 18, 2025

Este gusano amenaza el ecosistema de Europa
December 02, 2025

"Soy fan número uno": Maduro felicita a RT en su anivers...
October 17, 2025

Cachorros recién reclutados participan en el desfile Cí...
September 19, 2024

Corresponsal de RT llega a primera línea del frente en p...
November 27, 2025

Erupción en Kamchatka: volcán despierta tras 600 años
August 04, 2025

Trump: "Estoy decepcionado del presidente Putin"
November 19, 2025

Emir Kusturica: Hoy la Unión Europea es una organizació...
November 03, 2025

Cumbre climática de la ONU en Brasil enfrenta protestas
November 14, 2025

Intenta que su robot le ayude en la cocina y no sale bien
November 03, 2025

Pasajera queda atrapada en un tobogán sobre el océano d...
September 26, 2025

Encontronazo inesperado al salir de un estacionamiento en...
November 20, 2025

Democracia racial en Brasil: ¿mito o esperanza?
July 01, 2025

Un chico revive fotos antiguas de su abuela con IA
September 23, 2025

Maduro firma la ley de los comandos de defensa integral d...
November 11, 2025

Narco y crimen: epidemia en América
September 02, 2024

¿Opositora mexicana quiere la polémica guerra contra el...
February 12, 2024

Irán-Israel: espiral de venganza
April 17, 2024

Trump: Xi Jinping "quiere que vaya a China"
August 25, 2025

Investigan la posible muerte de dos trinitenses en el úl...
October 16, 2025

Petro lanza un dardo contra EE.UU. con este dato demoledo...
September 17, 2025

Rompe la maleta para no pagar un extra por el tamaño de ...
August 07, 2024

ELN muestra disposición para retomar diálogo, pero sin ...
September 09, 2025

‘Alegran’ a su hija con un anuncio de embarazo y así...
June 18, 2024

Asesor: Las partes están dispuestas a alcanzar una paz d...
December 02, 2025

Inventor chino deslumbra con flota de drones-espada al es...
December 06, 2025

Putin: Grandes proyectos conjuntos entre Rusia y la India...
December 05, 2025

Comunidades inmigrantes muestran su voluntad de defender ...
October 09, 2025

Ladrón robó una figura navideña y huye en motocicleta
December 01, 2025

Trump firma una orden ejecutiva para "salvar" TikTok de s...
September 25, 2025

Reportan al menos cuatro muertos y varios desaparecidos t...
September 05, 2023

⚡️El asesor de Putin revela la fecha de la visita de ...
November 26, 2025

Citan a declarar como investigada a la esposa de Pedro S...
June 04, 2024

Los países bálticos celebran la desconexión de la red ...
February 12, 2025

Reportes ponen en duda denuncia de intento de asesinato c...
October 09, 2025

Gobierno brasileño se reúne para abordar el megaoperati...
October 28, 2025

Ministro de Defensa ucraniano comenta reunión con delega...
June 02, 2025

Trump: "No estoy feliz con México"
November 17, 2025

🇺🇦🪖 Reclutadores ucranianos intentan movilizar a...
July 27, 2025

Pelea en la calle por cartel sobre ‘el odio a la derech...
September 22, 2025

Decenas de miles de israelíes abuchean a Netanyahu cuand...
October 11, 2025

Zelenski: “Ha llegado el momento de presionar más a Ru...
May 23, 2025

Un procedimiento inusual en China para "relajar los ojos"
December 01, 2025

Dolientes se despiden de víctima de operación policial ...
November 01, 2025

El primer ministro húngaro agradece a Rosatom y Gazprom ...
October 17, 2023

Esta maniobra de fondeo es una de las más peligrosas jam...
November 24, 2025

Frei Betto: El sistema occidental prioriza la muerte ante...
December 01, 2025

Delcy Rodríguez: "Rusia siempre podrá contar con Venezu...
November 27, 2025

Héroe en la carretera: así frenó un inspector un cami...
December 07, 2025

Denuncia discriminación porque le pidieron retirar bande...
December 01, 2025

Explosión cerca de una comisaría sacude una localidad i...
November 14, 2025

Venezuela acoge la Asamblea de los Pueblos por la Paz y l...
December 09, 2025

El gobierno de Río de Janeiro negocia medidas contra el ...
November 07, 2025

Putin revela las consecuencias de renunciar a la energía...
October 16, 2025

Obreros suben un vidrio sin ninguna medida de seguridad
July 07, 2025

"Ofensiva en un amplio frente": Jefe del Estado Mayor rus...
December 01, 2025

Conductora despistada en la carretera provoca un absurdo ...
August 29, 2025

Alas no tripuladas rusas salen de cacería
November 09, 2025

💪😫Una carga de entrenamiento que los fisicoculturis...
November 28, 2025

Líderes por encargo: figuras, caretas y mentiras
April 14, 2025

15 años muerto en casa sin que nadie lo notara
October 17, 2025

Solo 9 de 42 iglesias aceptaron ayudar a una mujer
November 13, 2025

Putin: "La tríada nuclear es garante de la soberanía de...
June 11, 2025

Un lugar donde hay más cangrejos que gente
October 31, 2025

Fuerte incendio en un edificio residencial ruso tras el i...
August 27, 2025

¿Tigre de papel?: Rusia responde a Trump con cifras tras...
September 25, 2025

Mujer sobrevive a un ataque con cuchillo de su pareja en ...
November 13, 2025

Niño le reclama a su papá por comprarse unos zapatos en...
October 22, 2025

Lavrov: No hay lugar para la UE en las negociaciones sobr...
September 17, 2025

Zelenski, la comedia que terminó en tragedia
November 27, 2025

Asesinan a dueño de un motel tras preguntar "¿estás bi...
October 10, 2025

Ucrania: plan tras bambalinas
November 20, 2025

🛢🇷🇺 "Rusia suministra alrededor del 10 % de la p...
October 16, 2025

Guardia de seguridad mata a dos delincuentes en intento d...
September 17, 2025

La primera reacción de Sheinbaum tras el acoso sexual qu...
November 05, 2025

Trump afirma que nunca fue a la isla de Epstein
July 25, 2025

Trump adelanta que EE.UU. realizará en América Latina o...
October 23, 2025

Dmitri Medvédev: "Ningún Estado profundo podría soport...
November 02, 2024

Trump sugiere que podría ir en unos días a Oriente Medi...
October 08, 2025

El Kremlin comenta la posibilidad de que Putin y Trump se...
July 28, 2025

RUDN: construyendo puentes - Documental de RT
October 12, 2025

Focas bailan al ritmo de la música clásica
September 03, 2025

Europa: censura y control
December 08, 2025

Consejo inesperado para mujeres que buscan el amor verdadero
November 06, 2025

Dragón de Komodo sorprende en hotel de la isla Manukan, ...
August 01, 2025

Confirman reunión entre EE.UU. y Ucrania en Arabia Saudita
March 07, 2025

Oficios en peligro: la lucha de la tradición en España
November 28, 2025

Trump: "Netanyahu es un héroe de guerra, y supongo que y...
August 19, 2025

No a todo el mundo le gustan los perros
September 17, 2025

Conductora de autobús rescata a un niño perdido durante...
November 27, 2025

Alerta de tsunami en Alaska tras terremoto de magnitud 7,3
July 16, 2025

Rafael Correa sobre el rechazo popular a las propuestas d...
November 17, 2025

Histórico: México y China sellan alianza espacial
August 19, 2025

"Trabajaremos para poner fin a estas atrocidades": Trump ...
November 19, 2025

Helicópteros rusos en acción durante ejercicios Západ-...
September 15, 2025

Supremo Tribunal Federal ratifica la condena a prisión c...
November 07, 2025

Diputado letón es expulsado del Parlamento por hablar en...
June 05, 2025

Sequías de 13 años: el fin de la civilización maya
August 19, 2025

Argentinos optan por el salto al torniquete en lugar de p...
February 23, 2024

La odisea de una joven para ingresar a su departamento en...
November 18, 2025

Museo exige 11.000 dólares a visitante por sentarse en t...
December 11, 2025

Milagro a la vista en China: una mujer de la limpieza cam...
November 18, 2025

"Todo lo que está ocurriendo es para nosotros una traged...
August 15, 2025

"La Agenda 2030 es un caballo de Troya de EE.UU."
November 24, 2025

"Occidente siempre ha sido muy tolerante a la mentira, pe...
November 10, 2025

El escenario principal de Tomorrowland se incendia
July 16, 2025

Senado de EE.UU. aprueba por unanimidad el proyecto de le...
November 18, 2025

Maduro: "Allá el norte imperialista, con sus palabras y ...
November 19, 2025

Esto ocurre cuando no se cumplen las medidas de seguridad
September 03, 2025

Trump se pronuncia sobre revocar visas a quienes celebran...
September 15, 2025

Cordial despedida de Putin a su homólogo kazajo
November 11, 2025

Al rescate del peluche ártico - Documental RT (Archivo R...
October 09, 2025

Moscú sobre la tensión en el Caribe
November 07, 2025

"Estructuras criminales" perpetran un atentado con explos...
November 19, 2025

Fuerte terremoto y tsunami en Japón deja siete heridos y...
December 08, 2025

La primera reacción de Trump a la detención de Bolsonaro
November 22, 2025

Adolescente apuñala a un guardia de seguridad tras un co...
November 24, 2025

Trump revela cuál es su palabra favorita
December 09, 2025

Rusia frustra un intento de sabotaje en vía férrea por ...
November 24, 2025
![Trump: “Ambos [Putin y Zelenski] quieren que esté allí”](https://1a-1791.com/video/fww1/10/s8/6/c/p/K/_/cpK_y.4Wpjb.jpg)
Trump: “Ambos [Putin y Zelenski] quieren que esté all...
August 16, 2025

Corte Constitucional de Ecuador convoca a autoridades y d...
November 21, 2025

Explosiones sacuden dos buques petroleros en el mar Negro
November 28, 2025

¿Cómo falló el sistema de seguridad del Louvre durante...
October 20, 2025

Elecciones en Honduras: ¿continuidad, alternancia o terc...
November 04, 2025

El Caribe enfrenta la tormenta del siglo
October 28, 2025

Alimentos que pueden ayudar a prevenir el cáncer
September 14, 2025

Así reacciona un niño al descubrir cuántos años debe ...
September 08, 2025

☢️💀 NÚCLEO DEL DEMONIO: El oscuro experimento que...
October 05, 2025

2 militares, tiroteados cerca de la Casa Blanca
November 26, 2025

Trump: El jueves es una fecha "apropiada" como plazo para...
November 21, 2025

"Europa solo piensa en una tregua, recuperar el aliento y...
December 11, 2025

Milei apela al Tesoro para contener el dólar a días de ...
September 02, 2025

Petro carga contra EE.UU. por la descertificación de Col...
September 18, 2025

El Ejército ruso captura a otro soldado ucraniano
November 11, 2025

El vocalista Bobby Vylan se defiende tras ofensas sobre C...
September 15, 2025

Putin responde si Rusia quiere volver al G8
December 04, 2025

Venezuela sobre despliegue militar de EE.UU. frente a sus...
November 01, 2025

Por qué es necesario pasear a los perros con correa
October 03, 2025

Durante un paseo habitual, una chica nota una vista hermosa
November 10, 2025

Trump califica de débil el ataque iraní a base de EE.UU.
June 23, 2025

Rechazo a exclusión de Venezuela, Nicaragua y Cuba de la...
October 02, 2025

Arce asumió el poder tras la dimisión de su predecesor ...
December 10, 2025

Trump propone a Rusia y Ucrania poner fin al conflicto en...
October 20, 2025

Así reacciona una joven mexicana al recibir la carta sob...
November 07, 2025

Ucrania se ha convertido en el destino final de decenas d...
December 03, 2025

🗣"Nadie se cree su propaganda"
September 19, 2025

Infancia con 35 libras: la carga invisible de los niños ...
May 23, 2025

“Noboa gobierna desde el miedo”
October 20, 2025

EE.UU. designa como narcoterroristas a dos grupos delicti...
September 04, 2025

Repelentes de mosquitos se compran masivamente en Argentina
April 06, 2024

Robo frenado: delincuentes escapan tras no poder llevarse...
October 08, 2025

Lavrov sobre Guterres: "Desvía la mirada avergonzado" al...
September 17, 2025

Alexánder Duguin: "Occidente busca mantener su dominio g...
October 26, 2025

Artista convierte moho en obras de arte
October 12, 2025

Críticas al TikTok de los Juegos Paralímpicos por músi...
October 27, 2025

Esposa del ex primer ministro nepalés reportada muerta e...
September 10, 2025

Gobierno de Argentina: El Hospital Garrahan recibirá má...
October 04, 2025

Enorme manada de renos bloquea una carretera en Rusia
November 21, 2025

Una taxista no permite que suba un pasajero debido a su peso
November 07, 2025

Ejecutan efigie de Netanyahu
October 25, 2025

Candidato a fiscal en EE.UU. gana luego de un polémico v...
November 05, 2025

Colombia y el drama creciente de sus exmilitares mercenarios
November 14, 2025

Una fan de Katy Perry se desmaya en pleno concierto
August 04, 2025

Lavrov: El régimen de Kiev se ha convertido en un grupo ...
December 11, 2025

Kremlin: Es mejor negociar ahora que más tarde
November 21, 2025

Felipe VI vuelve a la Comunidad Valenciana para conocer l...
November 12, 2024

Trump ya sabe qué le pedirá Zelenski esta semana
October 14, 2025

Explosión en balneario termal de Ahuachapán causa pánico
July 11, 2025

Riada se lleva por delante a varias personas en la India
September 17, 2025

Perro queda atrapado en el estante de verduras en un Walmart
August 16, 2025

Jugador de bádminton encuentra la manera de no perder ni...
November 17, 2025

El llamado del ministro de Defensa de Venezuela ante agre...
December 09, 2025

Plan de Trump sobre Gaza, Siria y programa nuclear iraní...
October 07, 2025

Trump: "Vi a Rusia celebrando el Día de la Victoria y pe...
November 11, 2025

EE.UU. prueba tecnología usada en Gaza para vigilar la f...
November 14, 2025

Europa sin soberanía: el declive político a la vista
August 01, 2025

Nidia Góngora llevará la música del Pacífico colombia...
September 18, 2025

De la cárcel al cambio: segundas oportunidades en Colombia
December 05, 2025

Buque de carga impacta contra un puente ferroviario en Rusia
May 27, 2024

CEO de Palantir genera sospechas por comportamiento extraño
December 10, 2025

Denuncian más muertes de menores en operativos militares...
November 19, 2025

"¿Quién de ustedes es mi mamá?"
November 14, 2025

Trump: "El mundo es EE.UU."
November 10, 2025

❌🐢 Polémica en Hawái por hombre que alzó una tort...
November 29, 2025

La Casa Blanca revela si Trump quiere aislar económicame...
September 10, 2025

Madre reta a su hijo por burlarse de un niño autista
September 08, 2025

Trump: "Si Milei pierde, no seremos generosos con Argentina"
October 14, 2025

Sonríes por fuera, rezas por dentro
December 09, 2025

Reino del cielo en la tierra - Documental RT (Archivo RT ...
November 14, 2025

Putin comenta el veto a Rusia en el G7
November 27, 2025

Zapadores norcoreanos ayudan en desminado a sus homólogo...
November 14, 2025

"El asesinato de Kennedy como pretexto para invadir milit...
May 21, 2025

La importancia de los humedales: un ciclo vital en peligro
June 20, 2025

🙏🥺 Rescatan a un lince que no podía bajar de un poste
November 02, 2025

Charlie Kirk, el polémico activista conservador asesinado
September 11, 2025

Trump: Detuve 6 guerras en lo que va de mi mandato
July 28, 2025

Reportan detención del expresidente de Bolivia Luis Arce...
December 10, 2025

Dron del centro ruso Rubicón destruye maquinaria ucraniana
November 13, 2025

Un método de publicidad original y poco convencional
October 07, 2025

🐻 Una fiesta de osos es interrumpida por un inesperado...
July 26, 2025

Los estudiantes de Caracas confirman disposición a defen...
November 21, 2025

Desaparece el joven que creó un reactor para convertir p...
July 29, 2025

Vendedora de una tienda rusa planta cara a un ladrón con...
November 05, 2025

Sepa más: 20 años de RT
December 11, 2025

Condenan al expresidente peruano Pedro Castillo a 11 año...
November 27, 2025

Los dos estados principales del juego del Monopoly
September 25, 2025

"Trump es el único de los líderes occidentales que comp...
December 10, 2025

Analista: Zelenski condena a los soldados ucranianos a un...
November 06, 2025

Varios países europeos más reconocen a Palestina como E...
September 23, 2025

🎤🤷♀️ Una famosa cantante española se discul...
November 29, 2025

Dictan prisión preventiva por abuso sexual contra menore...
July 27, 2024

Kremlin: Diferentes países intentarán socavar el acuerd...
November 26, 2025

Putin afirma que Rusia es el único país que construye p...
December 04, 2025

Tokáyev: "La amistad entre nuestros pueblos está predet...
November 12, 2025

Cancillería china: Primer ministro chino no se reunirá ...
November 17, 2025

Inspectora arruina la comida de un vendedor ambulante roc...
November 18, 2025

Pidió un florero pero lo que le entregaron la dejó boqu...
November 11, 2025

Venezuela suspende toda cooperación con Trinidad y Tobago
October 27, 2025

⚡️Un brasileño enfrentó hambre y abandono en Ucrani...
August 08, 2025

Descubriendo las Siete Hermanas de Moscú
October 24, 2025

Sabor y herencia: la cocina que une generaciones
September 14, 2025

Pegados a sus teléfonos, no se percatan de un peligro a ...
November 09, 2025

"Ucrania tiene problemas difíciles": Trump sobre el mega...
December 01, 2025

La estatua de una vaca creó ‘magia’ que un niño nun...
October 22, 2025

Macron rechaza un cambio de régimen en Irán
June 18, 2025

Supera un edificio de 200 metros: China inaugura un puent...
September 28, 2025

Trump y Ronaldo: "Los más grandes de todos los tiempos"
November 19, 2025

Sheinbaum critica propuestas de oposición sobre interven...
November 11, 2025

"Reunión en Alaska ha despertado la esperanza de una sal...
September 23, 2025

Pierde el control del coche debido a un dolor de cabeza
November 11, 2025

Oficialismo en Honduras desconoce los resultados electorales
December 08, 2025

Carlos Villagrán revive a Quico a los 81 años en Lima
July 28, 2025

"¡War no!": Maduro se dirige en inglés con un mensaje c...
November 14, 2025

Acuerdo de Dayton: el frágil equilibrio de la paz
December 02, 2025

“¿Trump se siente amenazado por los BRICS?”
July 07, 2025

Los cinco sentidos de Altái
September 01, 2025

Trump conversa con Sheinbaum y Carney durante el sorteo d...
December 05, 2025

Amistad rota por una deuda tras la compra de una PlayStation
November 28, 2025

Flávio Bolsonaro anuncia su candidatura presidencial par...
December 06, 2025

Terremoto de magnitud 5,5 sacude el centro de Bangladés
November 21, 2025

Cuando pedir azúcar para el café se convierte en un pro...
September 14, 2025

Así apoya un gato a su amigo tras una operación ocular
November 10, 2025

“El sistema occidental da más a la muerte que a la vid...
December 01, 2025

Brigitte Macron insulta a feministas llamándolas "sucias...
December 09, 2025

Emir Sader: América Latina frente al avance del neoliber...
September 15, 2025

Putin: Política de EE.UU. es un "vivo ejemplo del fracas...
October 10, 2023

La regla de oro para formar a los soldados, según la opi...
September 30, 2025

Crecen la incertidumbre y la tensión en Honduras
December 01, 2025

Gusanos y larvas: reparador de máquinas de café revela ...
August 26, 2025

Vladímir Putin y Xi Jinping conversan amigablemente ante...
August 31, 2025

China se prepara para el supertifón Ragasa
September 23, 2025

Un joven queda atrapado entre el andén y un tren en Madrid
May 05, 2025

Pomuch revive la tradición maya de limpiar los huesos po...
October 29, 2025

Indonesia se acerca a los BRICS con apoyo de Rusia y China
June 19, 2025

Rusia frustra atentado planeado por Kiev contra un gasoducto
November 29, 2025

"Si alguna de las potencias nucleares realizara pruebas d...
November 11, 2025

Detectan un error ortográfico en el cartel del jefe del ...
December 03, 2025

Trump: “Me reuniré con el presidente Xi”
October 20, 2025

“Ni siquiera Israel prohíbe el idioma árabe”
May 28, 2025

Atentado terrorista deja 5 muertos y 14 heridos en Colombia
August 21, 2025

ONU renueva Misión de Verificación en Colombia como par...
November 01, 2025

Todo sobre los resultados de las presidenciales méxicana...
June 03, 2024

Peter Szijjarto: “La UE bloquea las iniciativas de paz”
December 11, 2025

Brutal arresto por oficiales del ICE de un padre con sín...
November 07, 2025

Israel deporta a Greta Thunberg y a otros 170 activistas
October 06, 2025

Boric propone a Bachelet como candidata a la ONU
September 23, 2025

🌪🇯🇲Imágenes aéreas muestran las consecuencias ...
October 29, 2025

Policía confunde surtidor con pistola y crea falsa alarm...
October 11, 2025

El paro nacional cumple una semana en Ecuador con nuevas ...
September 29, 2025

El Pentágono muestra nuevo ataque letal contra una lanch...
October 03, 2025

Lavrov: Europa frena la resolución pacífica del conflic...
December 10, 2025

Un gato logra sortear la valla del árbol de Navidad
November 28, 2025

¿Existe un límite en la creación musical?
May 02, 2025

Intentaba ayudar, pero todo salió al revés
October 08, 2025

Los objetos que se han convertido en presa de ladrones en...
October 20, 2025

Casa Blanca: “Esta reunión se dará porque Putin la pi...
August 12, 2025

Trump afirma que el petrolero en las costas de Venezuela ...
December 10, 2025

CONAIE cesa el paro por represalias policiales y otras or...
October 23, 2025

El Kremlin sobre el escándalo de corrupción en Ucrania
November 18, 2025

Vladímir Putin da un discurso en el Desfile de la Victor...
May 09, 2025

Petro otorga la ciudadanía colombiana a Jorge Glas
September 17, 2025

Una paloma engordó tanto que ya no puede volar
November 17, 2025

Plan Cóndor: entre el pasado y el presente
December 01, 2025

Kallas insta a no apresurarse hacia la paz entre Ucrania ...
November 27, 2025

Merz critica a Orbán por su viaje a Moscú sin respaldo ...
November 28, 2025

Putin: "Construiremos con nuestros socios un marco común...
November 19, 2025

Ingenieros soviéticos desafiaron los límites de la tecn...
August 22, 2025

Argentina conmemora el Día de la Bandera
June 20, 2025

México propone a EE.UU. la integración regional
January 05, 2024

Reinstalan la audiencia del juicio del caso Las Malvinas ...
December 08, 2025

Trump: La "firma oficial" del plan de paz para Gaza será...
October 09, 2025

Tucker Carlson: A EE.UU. le interesa tener a Rusia como s...
December 11, 2025

Trump comenta el cierre del espacio aéreo venezolano en ...
December 01, 2025

Asesor ruso comenta la posibilidad de una reunión entre ...
December 02, 2025

Vicepresidente de Bolivia se pronuncia tras aprehensión ...
December 10, 2025

¡Rostov del Don, sorpréndeme si puedes!
June 14, 2024

El Ejército ruso libera Gnátovka en la República Popul...
November 10, 2025

Gata se sacrifica y salva a una familia de una serpiente ...
December 03, 2025

Putin: Los países occidentales no pudieron resistir la t...
October 02, 2025

¿Existe una misteriosa casa encantada frente al Kremlin?
October 31, 2025

Finaliza el campeonato de las Fuerzas Armadas de Rusia de...
November 24, 2025

Explota camión en Illinois, EE.UU., y daña varias vivie...
May 27, 2025

¿Se queda dormido Trump durante una reunión en el Despa...
December 03, 2025

Putin: Especialistas rusos logran inventar algo superior ...
July 06, 2025

Una forma inusual de descansar durante la jornada laboral
December 09, 2025

Putin revela que se mueve de incógnito por Moscú
December 09, 2025

Récord de edad: completa un Ironman a los 80 años
October 21, 2025

🎉🇨🇺Cuba felicita a RT por su aniversario
October 17, 2025

Joven sorprende a su amor con un tráiler de IA para pedi...
October 22, 2025

Putin elogia a las jóvenes de su país por conservar las...
October 02, 2025

Lula: "Ningún presidente de otro país puede opinar cóm...
October 17, 2025

Padrino: Venezuela se prepara para un "escenario de confl...
September 17, 2025

Gasta broma pesada a su novia en un restaurante
August 27, 2024

Experto analiza la política exterior de Argentina en cas...
November 19, 2023

TERMINAN las negociaciones entre Putin y Trump en formato...
August 15, 2025

Exministra de Arce da detalles sobre el arresto del exman...
December 10, 2025

La cámara de los coches LiXiang de China captura ‘fant...
September 18, 2024

VIDEO del momento en el que EE.UU. incauta un petrolero f...
December 10, 2025

Lamine Yamal se convierte en el jugador más joven en mar...
July 10, 2024

Así fuerzas rusas salvan vidas de soldados ucranianos qu...
November 23, 2025

“Necesitamos niños más sanos emocionalmente”
December 10, 2025

Lula responde a las críticas del canciller alemán sobre...
November 19, 2025

Maduro celebra elecciones como conquista revolucionaria e...
May 22, 2025

Lula propone reformar al FMI para "atender las necesidade...
July 07, 2025

El llamado de advertencia de Maduro al pueblo de EE.UU.: ...
November 14, 2025

Los grupos armados de Colombia "están dedicados puntualm...
October 16, 2025

Trump explica cómo estaría el mundo entero sin sus aran...
November 05, 2025

Los rohinyás: la nación inexistente - Documental RT (Ar...
October 23, 2025

Detienen en Perú a Pequeño J, acusado de un triple femi...
October 01, 2025

Lazos de sangre y fe
November 25, 2025

Rusia rastrea y aniquila a nacionalistas ucranianos
November 18, 2025

Putin: Es necesario reconocerle el mérito al presidente ...
December 04, 2025

Sánchez comete nuevo error de protocolo junto al rey Fel...
June 30, 2025

Trump increpa a Ramaphosa sobre el ‘genocidio’ blanco...
May 21, 2025

Casa Blanca comenta el "cerdita" de Trump a una reportera
November 21, 2025

Argentinos manifiestan su apoyo a Cristina Fernández a t...
June 11, 2025

Venezolanos se manifiestan contra las agresiones de EE.UU...
December 01, 2025

"Sí, este dictador es un hijo de p*ta, pero es nuestro h...
November 11, 2025

El ojo orwelliano al acecho
November 11, 2025

Lavrov: Un alto el fuego en Ucrania es una trampa de Occi...
July 15, 2025

Guardianes del manglar: vida y lucha en Ecuador
October 31, 2025

Venezuela realiza una operación antidrogas en medio de l...
September 17, 2025

Lavrov: "Abusaron del dominio del dólar y lo utilizaron ...
December 10, 2025

Mueren cinco mineros en presunto ataque del ELN en Colombia
November 06, 2025

Trump responde si planea hablar con Maduro
November 25, 2025

Nicaragua celebra 46 años de la Policía Nacional con su...
September 25, 2025

Trump promete operaciones terrestres contra los cárteles...
October 23, 2025

La vida en la región amazónica donde no hay acceso a la...
November 16, 2025

Intervisión 2025: Colombia lleva su canto ancestral a Mo...
September 18, 2025

Libertad con filtro oficial
October 23, 2025

Trump da un paso decisivo para la publicación de los arc...
November 19, 2025

🇨🇺 Cuba conmemora el 80.º aniversario de la victor...
May 03, 2025

Rusia y China a través de los tiempos - Documental RT (A...
September 16, 2025

Ladrón pero comedido: captan a un oso robando pescado en...
December 06, 2024

Relata una cita fallida y queda esperando solo con la cena
November 25, 2025

"¿Quién es Trump para decir que decide el destino de un...
November 11, 2025

Viktor Orbán propone Hungría para reunión entre Putin ...
November 28, 2025

Un hombre se opone al ‘romance’ de dos gatos
June 26, 2025

¿Cuán importante es Krasnoarmeisk, ciudad en Donbass li...
December 01, 2025

Trump revela el futuro de los aranceles contra la India
November 10, 2025

Ostional: refugio donde las tortugas luchan por sobrevivir
July 18, 2025

Trump amenaza con imponer aranceles a México por el agua
December 08, 2025

Despido fulminante de funcionario ruso tras inspección
October 16, 2025

Maduro: "EE.UU. ha sometido a Venezuela a una guerra mult...
September 16, 2025

Analista: El liberalismo se aprovecha de la pobreza de ex...
December 03, 2025

Sheinbaum y Lula refuerzan la alianza de México y Brasil
July 24, 2025

Un misterioso objeto iluminado sorprende a los habitantes...
November 11, 2024

El Kremlin confirma la fecha de la cumbre virtual de los ...
September 05, 2025

Una maniobra de la cual podría presumir hasta un piloto ...
July 14, 2025

Nueva ola de ayuda humanitaria a Gaza
July 29, 2025

Trump llega reforzado a una convención republicana
July 15, 2024

Asesor: Putin envió saludos a Trump y una serie de seña...
December 02, 2025

Estudiante extranjera muestra la abundancia de grafitis e...
August 25, 2024

Incendio devora rascacielos residenciales en Hong Kong
November 26, 2025

Maduro asiste al desfile militar para celebrar el Día de...
July 06, 2025

La razón para no colocar una vela en la mesa mientras se...
December 10, 2025

Primero ven maletas flotando… y luego entienden que son...
November 27, 2025

"Rusia se opone al uso de la fuerza por parte de EE.UU. e...
November 14, 2025

Fernández de Kirchner pide investigar a dos persona por ...
August 26, 2023

Fallece adolescente tras grabar un video en una vía ferr...
October 24, 2025

El símbolo vivo de México se cuela en plena avenida de ...
November 18, 2025

Maduro: Me critican por envidia
October 29, 2025

Dos genios, un paquete y el océano
November 27, 2025

Una decena de muertos tras choque entre autobús y tren
September 08, 2025

“Mi hermano, en realidad, estaba en Ucrania”
July 28, 2025

Israel ataca “un centenar de objetivos de Hamás” en ...
October 21, 2023

Capturan al conductor fantasma de Ferrari tras 6 años de...
September 11, 2025

Cuando la vida del campo se instala en un balcón
September 11, 2025

"Sos un rata": una joven termina una cita por esta insól...
November 07, 2025

Putin cita un proverbio kazajo durante su encuentro con T...
November 12, 2025

Lula espera tener una relación "civilizada" con EE.UU:
October 27, 2025

Logra mantener su casa con energía de residuos electrón...
October 15, 2025

Trump en la ONU: “He tenido razón en todo”
September 23, 2025

15 años de cárcel por asesinar a su exnovia en Reino Unido
July 23, 2025

Bomberos logran controlar un incendio en una estación de...
September 23, 2025

Putin hace balance de su visita sin precedentes a China
September 03, 2025

Oriente medio: conflictos enquistados
May 23, 2025

El Ejército ruso destruye tropas ucranianas con robots
December 08, 2025

Analista: Rusia y EE.UU. pueden "ir al fondo del asunto" ...
December 02, 2025

Trump comenta su primer encuentro con Musk tras meses de ...
September 22, 2025

"Inédito": Politólogo comenta la condena de Bolsonaro
September 12, 2025

¿Qué une a las culturas rusa y latinoamericana?
October 30, 2025

Procesan penalmente a diputado letón que defendió la le...
June 09, 2025

Turistas desoyen advertencias y se bañan pese a fuerte o...
December 09, 2025

Trump nombra una alternativa para Zelenski si no le gusta...
November 21, 2025

132 muertos tras la operación policial en las favelas en...
October 29, 2025

Barbados: de turismo y de isleños
October 10, 2025

🪖🇺🇸 Jefe del Pentágono reparte comida en el meg...
November 29, 2025

"¿Quién diría que presenciaríamos el declive de la he...
September 15, 2025

Astuto granjero inventor ayuda a salvar vidas durante fue...
November 28, 2025

Kremlin: Putin y Trump no quieren reunirse solo por "reun...
October 24, 2025

Ucrania: fracaso manifiesto
November 28, 2025

Pareja mexico-japonesa triunfa con palomitas hechas en Ja...
November 13, 2025

Madre y trinchera
October 20, 2025

Trump niega haber cedido la presidencia a Elon Musk
December 23, 2024

Muere Franz Beckenbauer, leyenda del fútbol alemán
January 08, 2024

Dmitri Peskov celebra el inicio de RT en la India
December 05, 2025

Bolivia: ¿Rumbo a Occidente o continuidad soberanista?
September 30, 2025

A mesero se le caen varias copas llenas y carga contra la...
December 03, 2025

Drones ucranianos atacan infraestructuras civiles en una ...
October 20, 2025

Maduro sobre la ofensiva de EE.UU.: "Es contra toda la Am...
November 14, 2025

Putin visita uno de los puestos de mando del Grupo Západ
November 20, 2025

Se descarrila el Tren Maya en México
August 19, 2025

Publicidad del concurso musical Intervision 2025 aparece ...
September 15, 2025

Histórico caso: jueza halla culpable a Álvaro Uribe de ...
July 29, 2025

Conquista la temida ‘escalera de la muerte’ en Chile
July 07, 2025

La huella soviética en uno de los videojuegos más popul...
September 23, 2025

Los cazadores de auroras - Documental RT (Archivo RT 2021)
November 05, 2025

Asesora de Biden: La renuncia de Ucrania a la OTAN habrí...
December 11, 2025

Trump se burla de haber ordenado el asesinato del general...
August 07, 2025

Recursos agotados: Bolsonaro comienza a cumplir la conden...
November 25, 2025

Concluye la reunión de Putin con Witkoff sobre el plan d...
December 02, 2025

Rusia lanza su primer submarino diseñado para el dron nu...
November 06, 2025

Zelenski admite que Ucrania ahora no tiene posibilidades ...
December 09, 2025

Lavrov se reúne con su homólogo cubano al margen de la ...
September 24, 2025

Kremlin comenta la operación lanzada por EE.UU. en el Ca...
November 14, 2025

Ciclista es atropellada tras discusión en una avenida de...
May 13, 2025

Prisionero ucraniano: "Nuestra propia gente quiso matarnos"
November 14, 2025

Un cometa ilumina el cielo nocturno de Moscú
November 07, 2025

Así felicitan en las calles a un perro que ha vencido el...
December 03, 2025

Maduro responde a las nuevas declaraciones de Trump sobre...
November 17, 2025

No subestimes el poder del karma
August 19, 2025

Una lluvia de fuegos artificiales causa incendio durante ...
October 03, 2025

Payasos desatan la polémica al grabar un video con niño...
December 05, 2023

Luis Arce se encuentra en las celdas de la Fuerza Especia...
December 10, 2025

Una decena de agentes unen esfuerzos para retirar a un en...
December 06, 2025

Máquinas de Coca-Cola entregan refrescos a cambio de abr...
November 17, 2025

En Venezuela jóvenes salen a las calles a favor del resp...
November 13, 2025

Tiktokers se burlan de la seguridad del Louvre y colocan ...
November 18, 2025

Algunos de los operativos policiales más sangrientos con...
October 30, 2025

"Pudo haber sido un error": Trump comenta el incidente co...
September 11, 2025

Venezuela emplaza a la ONU: "No hay una confrontación co...
November 13, 2025

Delincuentes apuntan a niña de 13 años durante asalto e...
May 28, 2025

Jefe del OIEA critica la incapacidad de la ONU para resol...
September 26, 2025

Trump: "Acabamos de incautar un petrolero en las costas d...
December 10, 2025

Un oso entra a una casa en EE.UU. y asusta a los residentes
August 29, 2025

Maduro: "Venezuela no es un país de delincuentes, es un ...
November 18, 2025

Amenaza a comensales en un restaurante y lo expulsan de e...
October 11, 2025

"Experiencia obtenida en la operación militar especial"
September 16, 2025

El ataque de EE.UU. a la narcolancha "no ocurrió", dice ...
September 04, 2025

¿Y el trineo con renos?: el Pentágono presenta a Papá ...
December 06, 2025

La niña más bella del mundo años después
October 12, 2025

El conflicto en Ucrania es "existencial para la OTAN"
July 28, 2025

Trump y su equipo de seguridad abordarán el tema de Vene...
December 01, 2025

Una familia tiene que comer de noche en la calle al imped...
December 01, 2025

Barbados, entre el lujo turístico y las carencias locales
October 10, 2025

Un gran ventilador ‘se rebela’ y casi aplasta a una m...
July 28, 2025

Tesla Optimus, el robot humanoide que aprende tareas del ...
May 21, 2025

Encuentros del papa Francisco con líderes del mundo
April 21, 2025

Concluye la reunión de Putin con Witkoff tras casi 5 horas
December 02, 2025

China advierte a Japón por comentarios sobre Taiwán
November 14, 2025

Migrantes venezolanos denuncian las "torturas y violacion...
September 10, 2025

Estatuas de traidores reciben golpes e insultos en China
November 19, 2025

Trump comenta sobre las veces que Netanyahu le pidió armas
October 13, 2025

Rusia muestra el poderío de sus drones en primera línea
November 12, 2025

El debate de una pareja sobre tareas domésticas desata p...
December 08, 2025

Vuela 8 horas sin persiana en la ventanilla
September 01, 2024

¿Reacción justificada o falta de respeto?
August 12, 2025

El magnate que superó a Elon Musk como la persona más r...
September 15, 2025

Presidente interino de Perú juramenta a ministros tras v...
October 15, 2025

Alcalde mexicano dispara al aire en pleno festejo patrió...
September 16, 2025

Trump dice que hubo más barcos atacados en el Caribe
September 16, 2025

Maduro explica las medidas de Caracas para evitar que buq...
September 15, 2025

Ejército ruso libera localidades y derrota tropas ucrani...
October 27, 2025

✊Protestas anti-Trump a gran escala tienen lugar en EE.UU.
October 19, 2025

Telegram ahora te permite mostrar música en tu perfil
September 02, 2025

Sin comida ni ropa de abrigo: soldado describe la precari...
November 28, 2025

Asalto violento a una panadería en Argentina
December 08, 2025

Jóvenes ucranianos huyen masivamente del país tras perm...
August 28, 2025

¡Erick viaja al polo norte!
October 10, 2025

Cae en una alcantarilla al bajarse de un mototaxi en Lima
February 19, 2025

🙈 Jennifer López pierde la falda en pleno show
July 27, 2025

Helicóptero pierde el control y se estrella en una playa...
October 12, 2025

Mujer salta mostrador en restaurante y se sirve su propia...
June 04, 2025

Maduro: "Los venezolanos están dispuestos a defender su ...
November 27, 2025

Peskov: Putin recibió informes sobre la situación en el...
November 20, 2025

Brasil condena la amenaza de EE.UU. de usar la fuerza mil...
September 10, 2025

Trump: "No queremos entrar en guerras"
November 05, 2025

Acallando a los críticos
April 25, 2024

Lula da Silva: En lugar de defenderse, Bolsonaro pide amn...
September 10, 2025

Putin revela qué palabras le dijo a Trump al saludarse e...
August 15, 2025

“Muy buenas conversaciones”: Trump sobre la reunión ...
August 06, 2025

Los países de occidente presionan con actitudes monopol...
December 02, 2025

El legado de Oliver Tambo
April 03, 2025

Congreso peruano inicia el camino para destituir al nuevo...
October 16, 2025

Experto: "El régimen de Israel no puede vivir sin que ha...
September 17, 2025

Laureano Ortega: "Es un honor firmar estos acuerdos de co...
September 22, 2025

"La red digital es la nueva herramienta de la dictadura"
December 01, 2025

Disparan con un rifle de asalto a un policía y a dos civ...
July 28, 2025

Anciano de 93 años gana Copa de Halterofilia de Rusia
November 23, 2025

Detalles del fallido plan de Kiev y Londres de secuestrar...
November 11, 2025

Estos vegetales protegen el cuerpo del daño del azúcar
October 14, 2025

Invitan a Putin a visitar Kazajistán y lo acepta con placer
November 12, 2025

Trump: “Nunca fui a esa isla”
July 28, 2025

Trump comenta el ataque de EE.UU. contra un barco de "nar...
September 15, 2025

🕊 "Sudamérica, Latinoamérica y el Caribe quieren paz"
September 06, 2025

NICA: Descifrar el Big Bang - Documental RT (Archivo RT 2...
September 24, 2025

Incendio devora varios rascacielos residenciales en Hong ...
November 26, 2025

Putin da comienzo a la transmisión de RT en la India
December 05, 2025

Choferes se reúnen para definir posible huelga en Paraguay
September 17, 2025

Trump anuncia dónde será su nueva cruzada contra los c...
September 30, 2025

La vida en Barbados: entre turistas y locales
October 10, 2025

😲Primero confunde… luego sorprende
November 24, 2025

Trump duda de un posible ataque de China a Taiwán
October 20, 2025

Un robot humanoide aprende a hacer las tareas domésticas
November 11, 2025

Lavrov: "Por desesperación, Occidente intenta agravar la...
December 11, 2025

Drones rusos destruyen 5 vehículos blindados ucranianos
November 11, 2025

La curiosidad que atrapó a un niño en una máquina de j...
October 22, 2025

De Bretton Woods al BRICS: el viraje desde un orden dicta...
September 02, 2025

"¿Quiere comprar un Rolex?": la extraña respuesta de Tr...
November 10, 2025

Trump entra en modo robo con el petrolero incautado en la...
December 10, 2025

En España los oficios tradicionales intentan sobrevivir ...
November 28, 2025

🕺Trump realiza su baile característico frente a milit...
October 28, 2025

Cae un fragmento gigante de una antigua estación de esqu...
November 11, 2025

Explosión de un horno industrial en Argentina deja heridos
October 13, 2025

El Senado de EE.UU. hunde la resolución que buscaba impe...
November 06, 2025

Trump sobre los rompehielos: "Rusia tiene 48 y nosotros s...
November 27, 2025

Hiroshima, 80 años después: sus habitantes recuerdan la...
August 06, 2025

La detención de Arce es un "chivo expiatorio" político ...
December 10, 2025

Una diputada arremete contra Netanyahu por la masacre del...
November 11, 2025

"Reconocer que la guerra en Ucrania ha fracasado desencad...
November 30, 2025

Una chica de 24 años descubre el origen de la carne de v...
November 24, 2025

India reta a Occidente, que compra su petróleo a pesar d...
August 24, 2025

Putin: "Deja de beber, ponte los esquís"
February 29, 2024

🙍♀️💦 Mujer lanza paquete de 40 botellas de a...
November 26, 2025

Inauguran primera fase de distrito bautizado en honor a P...
October 09, 2025

Justicia restringe visitas a Cristina Fernández de Kirchner
November 19, 2025

Intenta pasar justo enfrente de un tranvía y acaba así
October 08, 2025

Viuda de Charlie Kirk: "No tienen idea de lo que acaban d...
September 13, 2025

Analista: "Mientras Irán actúa con prudencia, EE.UU., I...
February 03, 2024

Tensión por despliegue militar en Los Ángeles
June 10, 2025

Trump: Kiev recibió en efectivo una parte significativa ...
December 02, 2025

Camión cisterna se salva por centímetros de un derrumbe
July 30, 2025

Prisioneros ucranianos revelan la crítica situación en ...
November 12, 2025

Congreso de Perú declara persona non grata a Sheinbaum
November 06, 2025

Un hombre evita robo ingresando a una panadería
December 01, 2025

Enviado de Kremlin destaca "la histeria" de los medios oc...
December 05, 2025

ZEDE en Honduras: inversión, arbitraje y soberanía en j...
November 25, 2025

Trump lanza una dura amenaza a Petro
October 22, 2025

Putin propone ayudar a extranjeros cualificados que desee...
July 03, 2025

"Von der Leyen ha causado tanto daño a Europa como muy p...
December 09, 2025

Peludo visitante supervisa desde un árbol el trabajo de ...
November 14, 2025

Putin: La iniciativa está completamente en manos del Ej...
December 01, 2025

EE.UU.-China: "Guerras raras"
July 07, 2025

Sorteo de grupos para el Mundial de Fútbol 2026: México...
December 06, 2025

Ascienden a 64 los muertos por intensas lluvias en México
October 13, 2025

Maestra de baile se marea y los alumnos la emulan
December 01, 2025

😢 Así ha quedado un edificio residencial en Irán dev...
June 13, 2025

¿Un rodaje de Hitchcock?: Miles de pájaros abarrotan el...
October 11, 2025

Potente terremoto deja decenas de muertos en Afganistán
November 03, 2025

Mercenario colombiano denuncia secuestro por el Ejército...
December 02, 2025

Comandante ruso detalla la liberación de la estratégica...
November 11, 2025

Cámara Electoral invalida fallo que permitía a votar a ...
September 15, 2025

La Casa Blanca afirma que aún no se descarta una cumbre ...
October 23, 2025

Trump-UE: ¿guerra declarada?
December 10, 2025

Sheinbaum revira a Trump: "No estamos de acuerdo en trata...
July 01, 2025

Fallece el vice primer ministro de Cuba Ricardo Cabrisas ...
September 17, 2025

Mujer se salva de milagro de ser atropellada gracias a un...
November 11, 2024

Así reacciona una niña al ver un animal disecado
August 18, 2025

"¡Tantos millonarios y pasa esto!": Llora tras comprar g...
November 21, 2025

¿El gimnasio más hermoso del mundo? (y tiene cine)
October 09, 2025

Erdogan acusa a Israel de genocidio ante la ONU
September 23, 2025

Lavrov: "Ninguno de los vecinos de Israel puede sentirse ...
September 25, 2025

😍🌌 Impresionante vista de la Vía Láctea
November 16, 2025

Analista examina las posibles repercusiones por la detenc...
December 10, 2025

Joven armado muere tras intentar huir de la Policía
October 28, 2025

Activista: "La decisión sobre el diésel en Ecuador favo...
September 19, 2025

Trump: "¿Lanzaría ataques contra México para detener l...
November 17, 2025

🗣🇭🇺 Intérprete de Orbán no tradujo con precisi...
November 30, 2025

🌪🇭🇹Las consecuencias provocadas por el paso del ...
October 29, 2025

Trasladan a Bolsonaro "de emergencia" a un hospital
September 17, 2025

Zelenski: En cuanto a Crimea, hoy en día no tenemos fuer...
December 09, 2025

Maduro canta y baila al ritmo de Dont worry, be happy
December 10, 2025

Ataque de cohetes rusos contra las tropas ucranianas
November 13, 2025

Joven advierte del peligro de ducharse con la lavadora pu...
October 12, 2025

Experto analiza el verdadero objetivo del Gobierno bolivi...
December 10, 2025

El desayuno que alarga la vida
July 28, 2025

Despiden a empleada de Cinnabon tras insultar a una parej...
December 09, 2025

Israel lanza una ofensiva terrestre a gran escala en la c...
September 17, 2025

Médicos rusos mueven un automóvil a pulso
September 18, 2025

Manifestantes prenden fuego a las afueras del Parlamento ...
October 16, 2025

Amenaza de tsunami tras un potente terremoto en Japón
December 08, 2025

CICIH en Honduras: ¿comisión con dientes o gesto simbó...
November 18, 2025

Ucrania asegura “estar lista” para un alto el fuego
July 23, 2025

Japonés se enfurece contra turistas australianos por fumar
November 25, 2025

Activistas lanzan pintura roja a un cuadro de Cristóbal ...
October 12, 2025

Del encierro en cárceles colapsadas a la esperanza de re...
December 07, 2025

Choques con la Policía durante marcha multitudinaria de ...
September 14, 2025

Petro: "Trump está contra la humanidad"
November 06, 2025

Zelenski abandona la Casa Blanca tras finalizar su reuni...
October 17, 2025

Rodrigo Paz se erige como presidente electo de Bolivia
October 20, 2025

Pitón gigante sorprende a mujer dormida en su casa
October 01, 2025

El conflicto en Ucrania y el dilema estratégico de la OTAN
July 28, 2025

🇦🇷 Los sindicatos argentinos celebran una marcha po...
May 01, 2025

Turquía corta todo comercio con Israel en apoyo a Palestina
August 29, 2025

"Brasil tiene una gran deuda de memoria"
April 01, 2025

Prisionero de guerra ucraniano revela la dura realidad en...
November 10, 2025

En Oriente Medio acusan a Israel de arriesgar paz regiona...
January 03, 2024

Venezuela aprueba la ley de los comandos de la defensa in...
November 11, 2025

EE.UU. realiza otro ataque "letal" en el Pacífico y mata...
December 04, 2025

Profeta ghanés construye arcas ante temor a diluvio navi...
December 10, 2025

Mundial del 2026 en México: "denuncias de sitios falsos"...
June 13, 2025

Los hilos del poder
October 16, 2025

Las primeras lluvias tras meses de sequía causan un desp...
November 24, 2024

Así llevan a la escuela a los niños cuando llueve en Vi...
October 10, 2025

"Guerras que no son nuestras": Petro celebra la ley contr...
December 04, 2025

Un adolescente roba el coche de su madre para visitar a s...
November 12, 2025

Patrulla de camellos bloquea el paso vehicular en plena vía
October 10, 2025

El momento exacto en que Israel intercepta un barco de la...
October 01, 2025

Lleva un rifle para enfrentar a un ladrón en su casa y r...
August 25, 2025

Tiburón de más de dos metros es avistado en una playa e...
June 17, 2024

Trump sobre Gustavo Petro: "Espero que me escuche. Él se...
December 10, 2025

Estrategia de seguridad de EE.UU. deja clara la intenció...
December 06, 2025

Misteriosa espiral brillante aparece en el cielo
March 24, 2025

Aplastante detención de banda que extorsionaba a militar...
November 24, 2025

Putin "usa sus poderes de seducción"
August 15, 2025

Caballo Blanco: la carrera que une tradición e identidad
November 07, 2025

Combatientes rusos cuentan cómo liberan localidades
November 13, 2025

🚙 Este coche puede aparcar a la perfección sin ocupan...
November 29, 2025

Putin no quiere ni considerar el posible asesinato de Jam...
June 18, 2025

Ucrania desenmascarada
December 02, 2025

Flota del Pacífico rusa realiza simulacro de evacuación...
October 22, 2025

Guilherme Boulos: Hay fondos internacionales que se lucra...
September 29, 2025

Una ventana a Pakistán
November 29, 2025

Tras las huellas del tiempo
December 05, 2025

🇲🇽 México conmemora los sismos de 1985 y 2017 y re...
September 20, 2025

EE.UU. y China alcanzan un acuerdo sobre las futuras oper...
September 15, 2025

Estos son los dueños de las mayores fortunas de Latinoam...
October 12, 2025

Aurus: El Kremlin sobre ruedas - Documental RT (Archivo R...
October 16, 2025

El legado de la cantora del Pacífico colombiano
September 18, 2025

Así construyen puentes en China
August 04, 2025

Un conductor no cede el paso a un ciclista en un cruce pe...
November 13, 2025

Israel: genocidio probado
September 17, 2025

Trump sobre Ucrania: No les di nada
December 08, 2025

Explosiones cerca de un aeropuerto militar en Irak
June 30, 2025

Así fue el intento de golpe de Estado contra el expresid...
December 10, 2025

Trump sobre el conflicto ucraniano: "Creo que nos estamos...
November 25, 2025

Drones rusos no dan escapatoria a las fuerzas ucranianas
September 16, 2025

Lavrov: "No vamos a entrar en guerra con Europa, pero res...
December 10, 2025

Paraguay expulsa a criminal mexicano vinculado al Cártel...
September 18, 2025

Se abre un socavón en una carretera de Indonesia tras in...
December 04, 2025

Maduro: "La CIA históricamente trató de destruir Venezu...
October 31, 2025

Maduro agradece a Cuba por su "solidaridad, apoyo y cari...
October 17, 2025

"Confianza y respeto mutuo": Ministro de Defensa ruso se ...
September 23, 2025

Sismo de magnitud 6,4 causa daños y cortes de electricid...
June 07, 2025

Lavrov sobre el Vaticano como lugar para negociaciones co...
May 23, 2025

Fuerzas rusas hacen pedazos drones ucranianos
November 26, 2025

Maduro explica las razones del fracaso de EE.UU. en su "g...
August 25, 2025

Hay temas que se deben abordar por una cuestión de respo...
July 16, 2025

Renuncia la mano derecha de Zelenski ante el megaescánda...
November 28, 2025

Familia roba caramelos en Halloween en EE.UU.
November 01, 2025

Expiloto de F3 confiesa haber degollado a su padre
October 23, 2025

Hombre realiza arriesgada maniobra para despejar el paso ...
November 20, 2025

Putin destaca la colaboración en alta tecnología con la...
December 05, 2025

Sheinbaum pide que "pare el genocidio en Gaza"
September 22, 2025

Joven narra la final de la Copa Libertadores desde un cerro
December 02, 2025

Narendra Modi habla en la Cumbre del G20 como representan...
September 09, 2023

Del trastorno al arte - Documental RT (Archivo RT 2021)
November 05, 2025

Bolivia ante la difícil tarea de reanimar su economía
September 16, 2025

Pies veloces
November 07, 2025

Alias ‘Bujanka’: Una historia todoterreno
September 22, 2025

El hombre que renunció a los lujos para vivir sin techo
October 08, 2025

Flota del Norte rusa ensaya defensa contra ataques en Zá...
September 15, 2025

Trump: Rusia sí quiere poner fin al conflicto ucraniano
December 03, 2025

Maduro: "No es una tensión, es una agresión en camino d...
September 15, 2025

Pide una taza de agua en el aeropuerto, pero se la factur...
December 11, 2025

Como la comida del avión le gusta, elabora su propio plato
September 14, 2025

🎙"Cada vez más riqueza concentrada en menos manos"
November 30, 2025

Otty Patiño, consejero comisionado para la paz de Colombia
September 11, 2025

Washington habla del estado de negociaciones sobre Ucrania
December 01, 2025
Bacteria capaz de matar a una persona en solo 2 días afe...
June 21, 2024

Petro rechaza secuestro de militares por civiles presunta...
September 08, 2025

Maduro enciende la tarima al ritmo de un remix de sus pal...
December 10, 2025

Descubren el origen de un extraño chirrido en un coche
September 24, 2025

"¿Quién trabajaba en servicios de inteligencia: yo o us...
December 04, 2025

Macron abofeteado por su esposa al llegar a Vietnam
May 26, 2025
Making Digital Gold is a content viewing platform designed to facilty the viewing experianced.
Common Videos Categories